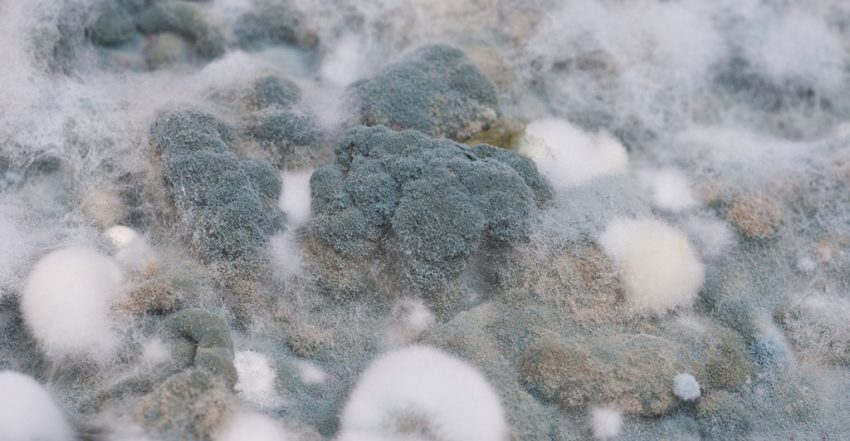
dealing with mould

7 Ideas for Dealing with Mould at Home
Mould is something you definitely don’t want to tolerate – it’s unsightly, stubborn, and difficult to expel. If you notice mould in your home, you need to act quickly and make everything possible to remove it. Besides being an ugly thing to look at, mould also poses a danger to your and your family’s health. Mould can damage our home and trigger severe health conditions, including eyes, nose and throat irritation, respiratory issues, headaches and sinus congestion, and even cancer.
However, dealing with mould is unlike any other chore in your house – you need to be sure you’ve eliminated all the reasons for its appearance. You must also see that you got rid of all the spores because if you don’t – the problem will reappear. Our cleaning experts share their tips on preventing mould and removing it from your home once and for all.
3 Tips on Mould Prevention
Humidity is often the main cause of mould growth, as mould and mildew are fungi that thrive in humid conditions. If you want to keep your home mould free, you need to keep the moisture at bay.
Keep Your Home Dry
Here are a few practical ways to control the humidity in your home:
- Hang your wet laundry to dry outside. If you don’t have suitable space, you can dry it in the bathroom with a window cracked open. Getting a tumble dryer is a good investment and helps minimise the humidity in your home, especially in winter.
- Put lids on the pots when cooking to reduce the evaporation of liquid. Remove the boiling kettle from the heat as soon as your water’s ready. Otherwise, half of it would go in the air.
- Don’t forget to turn the extractor hood when cooking.
- Install a powerful bathroom fan and run it while taking a shower.
- Wipe up wet kitchen worktops, bathroom tiles, and sinks after use.
- Keep the doors of the bathroom and kitchen shut when you are using the rooms, even if the fan is on, to prevent the humidity transfer to other areas of your home.

Let the Air Circulate
Having adequate airflow in the house is another thing you need to keep the humidity levels down and avoid mould growth.
- Crack open a window in the kitchen and bathroom every time you use the room. If there’s no window, make sure to run the extractor fan while cooking or taking a shower.
- Suppose you live in a particularly humid area. In that case, you need to aerate your cupboards, linen cabinets and wardrobes to prevent mould appearance.
- Leave at least 2 inches between your furniture and the walls. Don’t place beds and other large pieces of furniture near external walls, if possible.
Heating and Insulation
Another way to minimise mould and mildew appearance in your home is to invest in a high-quality heating system and proper insulation.
- Proper heating will keep your house warmer and minimise the humidity inside.
- Keep constant temperature with low background heating to reduce condensation in cold weather.
- If you live in a particularly humid area, consider investing in an air dehumidifier – a quality one that will help you lower the moisture in your home.
Read also: The Ultimate Autumn Cleaning Checklist to prepare Your Home for Winter

4 Tips on Removing Mould from Various Surfaces and Materials
If mould has already taken over your home, it is crucial to address the problem as soon as possible. Choosing suitable cleaning products and methods is a must if you want to prevent mildew and mould from reappearing. Here are a few easy and efficient ways to kill the spores causing mould growth in the most common areas of your home.
Check also: Our Detailed Room-by-Room Spring Cleaning Checklist
Bathroom Tiles and Grout
The bathroom tiles, grout, and corners are the most common spots where mildew and mould appear. Fortunately, cleaning this area is easy and doesn’t require costly tools and products.
- Mix a gallon of water with 1 cup of chlorine bleach.
- Apply the solution to the bathroom tiles using a sponge.
- Leave the product for 30 minutes, and then scrub the grout, corners, and tiles with a brush.
- Rinse the solution with clean water and dry the surfaces with a clean towel.
- Leave the door open to ventilate the area.
- Always wear gloves and a mask when using chlorine.
Read also: How To Clean The Bathroom Carpet
Fridge and Kitchen
All the food preparation and storage areas are susceptible to mould growth and foul odours due to the bacteria coming from the products we eat. The kitchen is also a humid area, which is a factor in the mildew appearance. Using toxic chemical cleaners when removing mould and bacteria from kitchen surfaces and refrigerators is not a good option, so we suggest the following substitutes:
- Hydrogen peroxide is a safe alternative to harsh chemicals that kills bacteria, causing mildew and mould growth.
- Use a sponge to apply the hydrogen peroxide directly to the affected surfaces.
- Wipe the surface with a clean towel.
- If you are cleaning a fridge, you’ll need to power it off. Let the inside aerate and dry thoroughly before storing food.
- If you don’t have hydrogen peroxide at hand, you can use a solution from 1 cup of white distilled vinegar and 1 cup of water.
Read also: How Often Should You Clean Your Fridge?
Clothes and Linens
If you forget to take out your gym clothes from the bag, or wet laundry in your washing machine, you will notice an odd, sweet-like smell in a few days. That is one of the first signs of bacterial growth. You can also see surface mildew spots. Use the following method to save your garments and linens:
- First, hang the affected items to dry completely. It is best to hang them out in the sun and leave them for at least a day so the fabrics can dry and aerate well. If not, you can hang the items in the bathroom with the fan running until they dry.
- We don’t recommend using your tumble dryer for the first step because the bacteria in your clothes and linens will transfer into the appliance.
- If you have to remove mould from your whites, wash them with bleach in your washing machine set to the highest temperature.
- If you are dealing with mould on your colour laundry, pre-soak it with non-chlorine bleach for half an hour, and then transfer it to the washing machine. Add 1 cup of baking soda to your laundry detergent. Set the temperature to the highest possible setting that won’t ruin the fabrics.
- After washing the clothes, hang them to dry immediately outside or in the bathroom with the fan running.
Carpets and Furniture
Removing mould from curtains, carpets, and upholstery is quite complicated. Sometimes spores get trapped between the fibres, so the problem reappears even when you clean the item vigorously. If you are dealing with mould on a small rug or removable piece of upholstery, you can try to treat it the same way you would treat clothes:
- Hang the item in the sun to dry and aerate well.
- Pre-soak with non-chlorine bleach.
- Wash in the highest temperature setting that won’t ruin the fabric.
- Hang in the sun to dry.
If you need to remove mould from a bigger carpet, it’s better if you don’t attempt to clean it by yourself. Instead, call experienced carpet cleaners and keep your fingers crossed. However, it’s best to throw the rug in some cases to prevent the mould from spreading around the house. Professionals use various cleaning methods to treat all kinds of floorings. If your carpet is salvageable – they’ll do their best to save it.